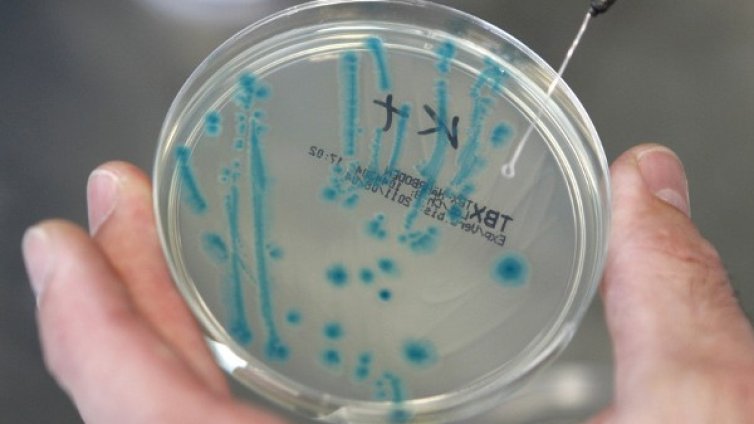
Кои са противотуморните антибиотици?

Новини
-
От трима кандидати избират ректор на Софийския университет
-
От днес се изплащат осъвременените пенсии
-
Днес ще е слънчево, с леки превалявания следобед
-
Грозен расистки скандал с Мбапе разтърси мондиала
-
Мондиал 2026: Белгия разгроми САЩ в битката на червените картони
-
Мондиал 2026: Испания победи Португалия с драма в края
-
Топмоделът Кейт Ъптън показа изцяло розовия си пентхаус в Ню Йорк
-
Турция забрани къпането в Черно море
-
Хотелиери и ресторантьори в Созопол: Сезонът започна повече от успешно
-
Шокираща версия за смъртта на принцеса Даяна – говори бивш агент на MИ-6
-
Белград илюстрира най-големия страх на ЕС - кандидат, който не иска да се промени
-
Земята преживя най-силната магнитна буря за 2026 година
-
РСМ след Мицкоски: По-далеч от ЕС, по-близо до Орбан
-
Слаб старт на сезона по Южното Черноморие, отчитат 30% спад
-
На фона на кризата с горивата: Продажбите на коне в Русия скочиха
-
Демерджиев за полетите на Пеевски и Атанасова: Има още много, които съвпадат по дати и участници
-
Слаб старт на сезона по Южното Черноморие, отчитат 30% спад
-
Зеленски: Боевете за Константиновка продължават
-
Емрах за гафа в Созопол: Всеки ден се случват най-лошите работи в нашата държава
-
Борисов: С казуса "Пеевски - Атанасова" местят фокуса от бюджета
-
Източният фланг на НАТО се готви за отбрана срещу Русия – със или без САЩ

Кадър на деня за 6 юли
Кадър на деня за 6 юли  Анкета: Докога ще продължи ралито при компаниите за чипове?
Анкета: Докога ще продължи ралито при компаниите за чипове?  Защо надделяват популистките тенденции в крайнодесния политически спектър
Защо надделяват популистките тенденции в крайнодесния политически спектър  Любомир Дацов: В средносрочната рамка не е планирано дефицитът да влезе в норма
Любомир Дацов: В средносрочната рамка не е планирано дефицитът да влезе в норма  Dow затвори над 53 хил. пункта за първи път
Dow затвори над 53 хил. пункта за първи път  Собственикът на "Северен поток" няма да получи застраховка заради взривовете
Собственикът на "Северен поток" няма да получи застраховка заради взривовете 
 Църковен празник на 7 юли - кой ще черпи за имен ден?
Църковен празник на 7 юли - кой ще черпи за имен ден?  Времето във вторник, 7 юли: Слънчево начало на деня, следобед валежи
Времето във вторник, 7 юли: Слънчево начало на деня, следобед валежи  Дневен хороскоп за 7 юли 2026: Какво са подготвили звездите за всяка зодия
Дневен хороскоп за 7 юли 2026: Какво са подготвили звездите за всяка зодия  От Helpbook: Къде е редно да стоят кофи, които са частна собственост?
От Helpbook: Къде е редно да стоят кофи, които са частна собственост?  Ново хапче за отслабване предизвика бум във Великобритания
Ново хапче за отслабване предизвика бум във Великобритания  Роналдо не сдържа сълзите си след последния мач в шестото си Световно (СНИМКИ)
Роналдо не сдържа сълзите си след последния мач в шестото си Световно (СНИМКИ) 
 Винисиус се преклони пред Холанд
Винисиус се преклони пред Холанд  Рубен Аморим пристигна в Милан: В този клуб винаги играеш само за победа
Рубен Аморим пристигна в Милан: В този клуб винаги играеш само за победа  Ориана Сабатини
Ориана Сабатини  Белгия помете САЩ и си уреди мегасблъсък с Испания на Мондиал 2026
Белгия помете САЩ и си уреди мегасблъсък с Испания на Мондиал 2026  Борац Баня Лука – Левски
Борац Баня Лука – Левски  Спортът по телевизията днес, 7 юли
Спортът по телевизията днес, 7 юли 
 Нумерологична прогноза за 7 юли
Нумерологична прогноза за 7 юли  Леки протеинови храни за лятното меню
Леки протеинови храни за лятното меню  Лилиум – как да го отглеждаме и да расте красиво
Лилиум – как да го отглеждаме и да расте красиво  Таро карта за 7 юли, вторник
Таро карта за 7 юли, вторник  Здравословен чиа пудинг с тъмен шоколад
Здравословен чиа пудинг с тъмен шоколад  Юли обръща плановете на някои зодии: Ето кой ще спечели най-много
Юли обръща плановете на някои зодии: Ето кой ще спечели най-много 
 продава, Двустаен апартамент, 61 m2 Варна, м-т Пчелина, 155000 EUR
продава, Двустаен апартамент, 61 m2 Варна, м-т Пчелина, 155000 EUR  продава, Двустаен апартамент, 61 m2 Варна, м-т Пчелина, 155000 EUR
продава, Двустаен апартамент, 61 m2 Варна, м-т Пчелина, 155000 EUR  продава, Къща, 136 m2 Варна област, с.Аврен, 97800 EUR
продава, Къща, 136 m2 Варна област, с.Аврен, 97800 EUR  продава, Тристаен апартамент, 110 m2 Варна, Колхозен Пазар, 210000 EUR
продава, Тристаен апартамент, 110 m2 Варна, Колхозен Пазар, 210000 EUR  продава, Многостаен апартамент, 150 m2 София, Малинова Долина, 418616 EUR
продава, Многостаен апартамент, 150 m2 София, Малинова Долина, 418616 EUR  продава, Къща, 150 m2 Варна, м-т Боровец - юг, 290000 EUR
продава, Къща, 150 m2 Варна, м-т Боровец - юг, 290000 EUR 
 Григор Димитров отпадна след петсетова драма на "Уимбълдън"
Григор Димитров отпадна след петсетова драма на "Уимбълдън"  Черно море представя отбора за новия сезон в събота
Черно море представя отбора за новия сезон в събота  Катя Дафовска претърпя тежка катастрофа
Катя Дафовска претърпя тежка катастрофа  България и Турция замразиха договора с "Боташ" за 15 месеца
България и Турция замразиха договора с "Боташ" за 15 месеца  Тръмп: Путин и Зеленски искат да сложат край на войната
Тръмп: Путин и Зеленски искат да сложат край на войната  Иван Иванов влезе в основната схема на турнир в Нотингам
Иван Иванов влезе в основната схема на турнир в Нотингам 
 Мистериозни сфери шокираха хора на австралийски плаж: Вероятно са части от ракета
Мистериозни сфери шокираха хора на австралийски плаж: Вероятно са части от ракета  Съставът на 3I/ATLAS потвърди произхода ѝ: От система със звезди, по-стари от Слънцето
Съставът на 3I/ATLAS потвърди произхода ѝ: От система със звезди, по-стари от Слънцето  Астероидът Апофис ще премине опасно близо до Земята през 2029 г.
Астероидът Апофис ще премине опасно близо до Земята през 2029 г.  Бивша служителка обвини НАСА, че премахва НЛО от сателитни снимки преди публикуване
Бивша служителка обвини НАСА, че премахва НЛО от сателитни снимки преди публикуване  Към Луната и Марс: Технологиите и откритията, които ще променят света в следващите 25 години
Към Луната и Марс: Технологиите и откритията, които ще променят света в следващите 25 години  Най-високите тропически дървета в света имат сложна защита срещу суша
Най-високите тропически дървета в света имат сложна защита срещу суша